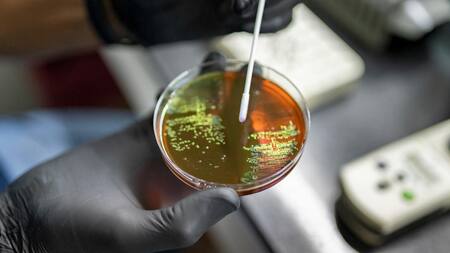
Encefalitis equina. Foto: Télam.

Encefalitis equina: el Ministerio de Salud confirmó la primera muerte en la provincia de Buenos Aires
La víctima de 74 años se encontraba internada desde diciembre. Del total de 10 casos, cinco de ellos aún continúan internados. Conocé más sobre la patología y sus prevenciones.

El Ministerio de Salud de la Provincia de Buenos Aires comunicó en la tarde de este jueves la primera muerte por encefalitis equina. La víctima fue una mujer de 74 años con comorbilidades proveniente de un área semirural.
A mediados de diciembre, la señora comenzó con los síntomas y había sido internada. Su enfermedad de base hizo que su estado de salud general se desmejorara repentinamente y necesitara ser internada en cuidados intensivos con asistencia mecánica.
Encefalitis equina. Foto: Télam.
Según informó el Ministerio, la provincia de Buenos Aires cuenta con un total de 10 casos: todos requirieron internación, uno falleció, cuatro de ellos recibieron el alta y cinco continúan internados en sus respectivos hospitales.
¿Qué es la encefalitis equina?
Es una patología neurológica que se transmite a través de picaduras de mosquitos infectados y, si bien afecta principalmente a los caballos, también puede transmitirse a las personas.
Justamente, en ellas, la enfermedad tiene un período de incubación de 2 a 10 días y si bien en la mayoría de los casos es asintomática, en ciertos casos puede presentar: fiebre, cansancio, dolores musculares y malestar general, los cuales desaparecen entre los 7 y 10 días.

Encefalitis equina. Foto: Télam.
Recomendaciones del Ministerio de Salud
- Aplicarse periódicamente repelentes de insectos con el ingrediente activo DEET mientras se realizan tareas en el exterior o dentro de establecimientos donde se hayan detectado animales enfermos o muertos. Es necesario volver a aplicar el producto periódicamente.
- Colocar telas mosquiteras en puertas y ventanas.
- Utilizar espirales en el exterior y pastillas o aerosoles en el interior de las edificaciones.
- Utilizar ropa clara y preferentemente de manga larga.
- Utilizar espirales en el exterior y pastillas o aerosoles en el interior de las edificaciones.
Medidas de saneamiento para evitar propagación
- Desmalezar predios y mantener el pasto corto.
- Eliminar o colocar bajo techo recipientes y otros objetos que puedan acumular agua.
- Evitar la acumulación de agua en el suelo.














